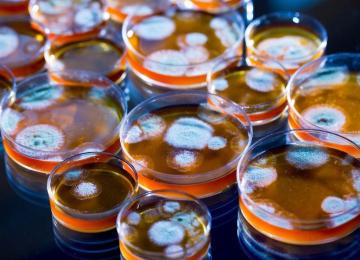

Engulfed in choking smog, some northern Chinese cities limited the number of cars on roads and temporarily shut down factories on Monday to cut down pollution during a national "red alert".
…People
Although the act of feeding stray animals or leaving them the remains of food may be out of love and sympathy, experts maintain that it does more harm than good.
"Professionally speaking,…
The euphoria over the rise in world tiger population early this year may have been misplaced for India, as the official data placed before parliament shows 98 tigers died in the country till…
According to official statistics, the number of Persian leopard deaths has declined from the beginning of the current Iranian year (started March 20) until Dec. 19, thanks to increasing fines and…
A senior lawmaker said on Sunday Iran cannot enact the Paris Agreement at present due to a "legal vacuum" caused by a lack of an action plan.
The population of mammals in Lar National Park has increased by 14% in the past 12 months, according to the park's director. "Eight survey teams, each comprised of three experts, prepared a report…
So far, 23 rare blood types have been identified in the country, said the head of Iran Blood Transfusion Organization. “Iran is among the world’s 23 countries which has a successful transfusion…
The past three weeks have seen the worst ever traffic congestion in Tehran this year. The freezing temperature and air pollution are some of the contributing factors that have apparently compelled…
A group of international academics has condemned a United Nations convention which bans child labor as “harmful and unnecessary”, arguing that allowing young children to work can have…
The Ministry of Health and the Ministry of Communications and Information Technology signed a memorandum of understanding on Thursday to promote e-healthcare services in rural…
More than 90% of all deaths in the country occur due to non-communicable diseases (NCDs). Cardiovascular diseases (46%), cancer (13%), and diabetes (2%), are the top three NCDs that have…
Under a memorandum of understanding with Tehran Urban and Suburban Railway Operation Company (Tehran Metro), a local knowledge-based company will begin studies to design and implement a project…
There are only two rehabilitation centers as of now that address the problem of drug abuse among school students across the country, said Mohsen Roshan Pazhuh, deputy for addiction prevention at…
Given the shortage of nomadic teachers, Iranian men eligible for conscription can seek exemption from military service by working as teachers in remote areas.
The 2016 Global Education Monitoring or GEM Report launched in Tehran last week, is the first in a newly mandated 15-year series, with the theme ‘Education for people and planet: Creating…
The increasing number of illegal abortions in the country is a cause for concern. Recently, 120 physicians in a letter to the health minster urged him to take stricter measures to prevent illegal…
The Office of the Vice Presidency for Women and Family Affairs has seen a 19% increase in the budget for the 2017-2018 fiscal year (starts March 2017), submitted to parliament on December 4. “The…
The Citizen Rights Charter will constitute a roadmap and a government program announcing citizen rights for all Iranians as well as developing, implementing and supervising the implementation of…
A 5-meter deep crater opened up in Tehran’s Molavi Street as a result of land subsidence on Saturday at 9 am. The incident occurred in a narrow old alley where the subway station’s ventilation…
Improving the quality of locally produced equipment and increasing domestic production will be an advantage for patients as well as the government, said scientific secretary of the first Annual…
The World Health Organization (WHO) has developed a fracture risk assessment tool (FRAX) which provides a ten-year major osteoporotic fracture risk prediction to patients aged 40 to 90 years, said…
The Imam Khomeini Relief Committee (IKRC) has brought 47,900 applicants on the waiting list under its coverage, since the beginning of the fiscal year in March till November.
The Ministry of Youth Affairs and Sports has announced it will complete the establishment of the so-called Youth Houses in all 31 provinces by the end of the current fiscal year in March 2017.
The production and distribution of Penicillin 6.3.3 has been resumed after laboratory tests at the Food and Drug Administration cleared the drug as safe for use.
“The lab results show the…
A brave teacher, Alireza Saqi, saved the lives of his students by evacuating them safely when an oil heater burst into flames in his classroom at a primary school in Hamamlou village in Ardebil…